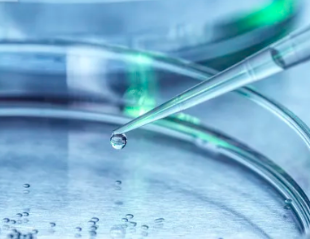
image.png

河北醫(yī)美干細胞存儲有意義嗎?如何選擇最佳存儲方案?
2024-10-31 13:49:57 來源: 小編 咨詢醫(yī)生
隨著科技的發(fā)展和人們對美的追求,醫(yī)美行業(yè)逐漸成為熱點。在醫(yī)美領(lǐng)域,干細胞存儲成為了一個備受關(guān)注的話題。那么,河北醫(yī)美干細胞存儲有意義嗎?如何選擇最佳存儲方案?本文將為您詳細解析。
一、河北醫(yī)美干細胞存儲的意義
1.促進組織修復(fù)與再生:干細胞具有自我更新和分化能力,可以分化成多種細胞類型,如皮膚細胞、軟骨細胞等。在醫(yī)美領(lǐng)域,干細胞存儲可以幫助修復(fù)受損組織,促進皮膚再生,達到美容抗衰老的效果。
2.提高免疫力:干細胞存儲可以為人體提供源源不斷的免疫細胞,增強人體免疫力,預(yù)防疾病。
3.預(yù)防和改善疾?。焊杉毎鎯梢詾閷砜赡馨l(fā)生的疾病提供治療資源,如心血管疾病、神經(jīng)系統(tǒng)疾病等。
4.個性化美容方案:干細胞存儲可以為個人定制化美容方案提供依據(jù),使美容效果更加精準。
二、如何選擇最佳干細胞存儲方案
1.選擇正規(guī)機構(gòu):選擇有資質(zhì)、信譽良好的醫(yī)美機構(gòu)進行干細胞存儲。這些機構(gòu)擁有先進的實驗室設(shè)備和專業(yè)的技術(shù)團隊,可以確保干細胞存儲的安全性和有效性。
2.了解存儲技術(shù):目前市面上有多種干細胞存儲技術(shù),如凍干技術(shù)、液氮存儲等。了解各種技術(shù)的優(yōu)缺點,選擇最適合自己需求的存儲方式。
3.考慮價格與性價比:價格是選擇干細胞存儲方案的重要因素之一。在了解價格的同時,要關(guān)注存儲服務(wù)的質(zhì)量和技術(shù)含量,選擇性價比高的方案。
4.關(guān)注存儲周期:不同存儲方案有不同的存儲周期,要根據(jù)個人需求選擇合適的存儲周期。一般來說,長期存儲可以確保干細胞的質(zhì)量和活性。
5.了解存儲后的使用方式:了解干細胞存儲后如何應(yīng)用于美容抗衰老等領(lǐng)域,以便在需要時能夠快速投入使用。
6.咨詢專業(yè)人士:在做出決策前,可以向?qū)I(yè)人士咨詢,了解干細胞存儲的相關(guān)知識,以便做出更加明智的選擇。
總之,河北醫(yī)美干細胞存儲具有很高的意義。在選擇最佳存儲方案時,要從正規(guī)機構(gòu)、存儲技術(shù)、價格、存儲周期、使用方式等多方面進行考慮,確保干細胞存儲的安全性和有效性。同時,關(guān)注我國醫(yī)美行業(yè)的發(fā)展,緊跟科技潮流,為美麗人生保駕護航。
- 2024-10-28乳牙干細胞儲存機構(gòu)大連哪家可靠?如何選擇?
- 2024-08-27南京儲存干細胞的價格,不同類型干細胞儲存費用
- 2024-10-20重慶醫(yī)美干細胞存儲哪家機構(gòu)更可靠?
- 2024-11-28存儲的干細胞怎么用,有哪些使用方式
- 2024-10-17干細胞存儲費用,干細胞存儲有必要嗎
- 2024-10-22山東肝硬化干細胞存儲哪家醫(yī)院靠譜?費用如何?
- 2024-09-13干細胞移植排異期多久,如何應(yīng)對排異反應(yīng)
- 2024-09-12蘋果干細胞價格是多少,一盒能用多久
- 2024-09-18干細胞療法效果好嗎,可以治療哪些病
- 2024-08-13脂肪干細胞抗衰老效果怎么樣
- 2024-09-03骨髓間充質(zhì)干細胞用什么培養(yǎng)基
- 2024-08-03自體干細胞抗衰,自體干細胞抗衰的優(yōu)缺點
- 2024-10-11造血干細胞捐獻的意義是什么?如何提高大眾對其認識?
- 2024-09-30干細胞治療原理是什么,新藥技術(shù)有哪些進展
- 2024-10-11干細胞在未來醫(yī)療中有哪些突破性應(yīng)用?其治療潛力如何體現(xiàn)?
- 2024-09-05石家莊干細胞機構(gòu)排名榜單最新
- 2024-07-18干細胞能治愈肝硬化嗎,干細胞對肝硬化的作用和功效
- 2024-09-27商洛的干細胞存儲機構(gòu)哪家可靠,選擇標準有哪些
